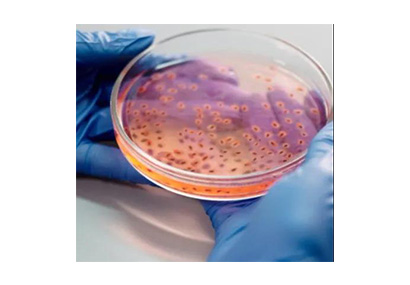

阿特拉斯·科普柯管道过滤器滤芯UD+介绍
阿特拉斯·科普柯管道过滤器滤芯UD +拥有鹦鹉螺过滤器技术,...
了解详情
阿特拉斯·科普柯管道过滤器滤芯UD +拥有鹦鹉螺过滤器技术,...
了解详情
阿特拉斯Elektronikon电脑控制器具有以下功能;控制压缩机,保护压缩机,监控保养条件下的元件,断电后自动重新起动....
了解详情
名义的压缩空气需要量取决于空气的消耗者。计算方法是将全部工具,机器设备,和相连流程等的空气消耗量相加而得。...
了解详情
阿特拉斯·科普柯过滤器通过ISO 8573 - 1:2010标准。适用于众多应用场合的解决方案。...
了解详情
空气干燥器和后冷却器是有助于保持压缩空气干燥的两件设备。干燥器用于去除压缩空气中的水分。...
了解详情
原则上说,最终用户加上空压机与使用设备之间的压力降 ,便是空压机需要产生的压力...
了解详情